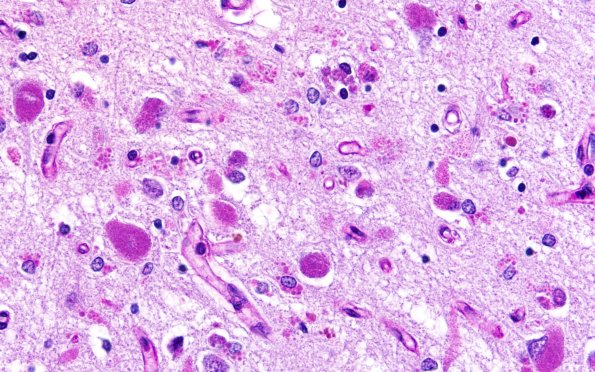
11C2 NCL (Case 11) PAS N3 temporal lobe 60X 3

Table of Contents
Washington University Experience | METABOLIC | Neuronal Ceroid Lipofuscinosis (NCL) | 11C2 NCL (Case 11) PAS N3 temporal lobe 60X 3
PAS stains demonstrate that the material in the temporal neocortex is diastase resistant, thus demonstrating the glycoprotein consistency of the substance.